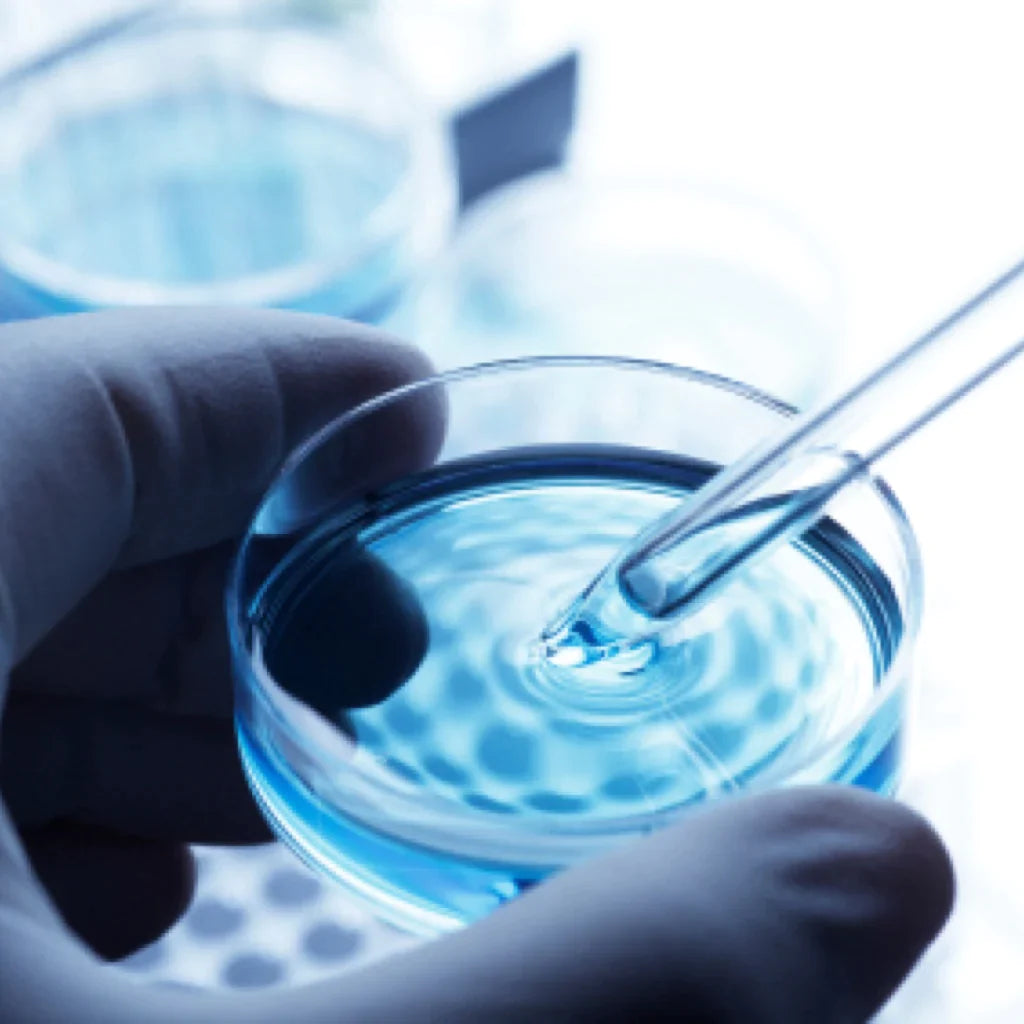

Collections
-

Care Home Air Purifiers
The risk of airborne infection in care homes is greater than in...
-

Cigar Smoke Air Purifiers
Cigar smoking is an increasingly popular activity. Despite a ban on smoking...
-

Construction Air Purifiers
Managing the high levels of dust and particulate matter during construction and renovation...
-

COSHH Regulations
COSHH (Control of Substances Hazardous to Health) is the law that requires...
-

Dental Air Purifiers
Routine dental work can expose dentists, their patients, and staff to airborne...
-

Dental Laboratories
Dental laboratories can benefit from having an effective air pollution control systems in...
-

Formaldehyde Air Purifiers
Formaldehyde is a chemical that is widespread in the environment. It is...
-

Gym Air Purifiers
Sports clubs, gymnasiums, and spas can be an important part of your life, both...
-

Hospital Air Filtration
Airborne transmission is a known route of infection for diseases such as...
-

Hotel Air Purifiers
Hotels across the UK deal with a wide range of airborne contaminants,...
-

Isolation Rooms
Protecting patients, staff and visitors in medical environments from airborne contamination and infectious disease...
-

Laboratory Air Cleaning
Laboratory air cleaning is a top priority for many laboratories, as the...
-

Nail Work Air Purifiers
Professional nail work air purifiers helps to keep the air in your nail salons clean...
-

Nursery Air Purifiers
Commercial Air Filtration works closely with nurseries to create clean and safe...
-

Office Air Purifiers
"Poor indoor air quality reduces productivity by up to 9% – that’s half...
-

SBS (Sick Building Syndrome)
Sick building syndrome (SBS) refers to a collection of symptoms caused by...
-

School Air Filtration
School air filtration is essential, as school children are particularly vulnerable to...